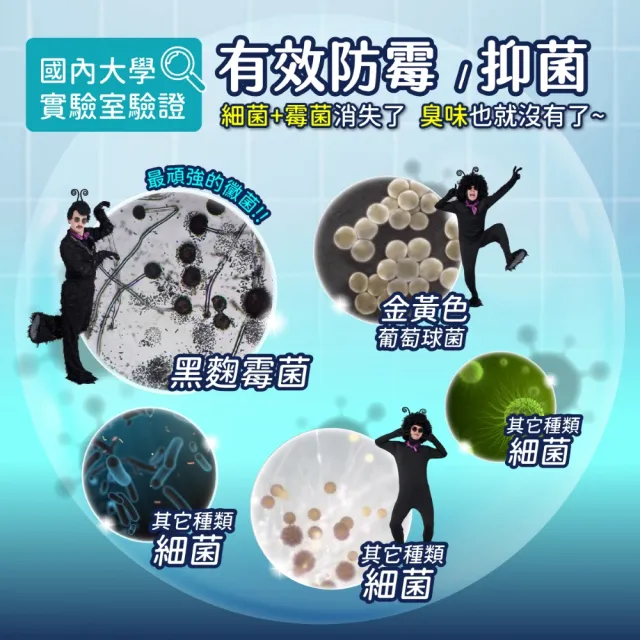
【鱷魚】鱷魚除霉防霉組(木隱之森)

掃除必備!防霉抑菌除臭一次搞定
品號:14299373
鱷魚 鱷魚除霉防霉組(木隱之森)
-
$499
促銷價
-
$759市售價
| 折價券 | 特惠商品,不適用折價券 | |
|---|---|---|
| 品牌名稱 |
鱷魚追蹤 |
|
| 付款方式 | 刷momo卡消費回饋最高3%! | |
| 配送方式 |
|
|
| 商品規格 | 請選擇 | |
可參加以下優惠活動
看更多「家用清潔」熱門商品
- #除霉
- #防霉
- #鱷魚
- #古寶無患子
- #神奇檸檬
商品評分
- 防霉抑菌有效防霉99.99%!
- 煙霧滲透 效果長達4~8週!
- 凝膠設計簡單方便好清潔!
| 品牌名稱 | |
|---|---|
| 香味 |
|
| 區域 |
|
| 類型 |
|
| 容量 |
|
| 配件 |
|
品名: 鱷魚防霉抑菌煙劑-木隱之森
有效成分:防霉抗菌劑、發煙劑、樹脂
內容量:10g
有效限期: 3年
生產地: 台灣
品名: 家能淨強效除霉凝膠
有效成分:次氯酸鈉、氫氧化鈉、增稠劑、香精
內容量:100ml
有效限期: 3年
生產地: 台灣
有效成分:防霉抗菌劑、發煙劑、樹脂
內容量:10g
有效限期: 3年
生產地: 台灣
品名: 家能淨強效除霉凝膠
有效成分:次氯酸鈉、氫氧化鈉、增稠劑、香精
內容量:100ml
有效限期: 3年
生產地: 台灣
商品組合:
鱷魚防霉抑菌煙劑*2+家能淨強效除霉凝膠*2
商品認證:
無須商檢
- 商品到貨享十天猶豫期之權益(注意!猶豫期非試用期),依法辦理退貨商品必須是全新狀態且包裝完整(包含主機、附件、內外包裝、隨機文件、贈品等)。如商品一經拆封或使用致商品價值受損(例僅得以福利品出售),momo將向消費者就商品一部或全部價值減損收取適當之費用(回復原狀、整新費),否則將影響退貨的權限。請先確認商品正確、外觀可接受,再行開機/使用,以免影響您的權利,祝您購物順心。各類商品退換貨限制說明
- momo出貨已全程攝影,為保障您購物權益,開箱過程請全程錄影;如有問題請反映客服並提供錄影檔案,祝您購物愉快。
- 下載版序號、珠寶、黃金類訂單之商品暫不提供線上退/換貨,3C類商品暫不提供換貨服務,其它商品僅限換貨1次。
- 個人衛生用品除商品本身有瑕疵外,未拆封商品仍享有十天猶豫期之退貨權利。但已拆封 (如剪標、下水等情形…),依據《通訊交易解除權合理例外情事適用準則》,本公司無法接受退換貨。
※個人衛生用品:泛指與肌膚及人體私密處接觸之商品,例如:內衣褲(含隱形胸罩、胸扥、胸貼、透明肩帶、水餃墊/美胸墊、襯裙)、塑身衣(含馬甲、束褲、束腿、腰夾、內搭)、泳裝、襪子、紙尿褲、牙刷….等。 - 我們所提供的產品配送區域範圍目前僅限台灣本島。
- 商品之實際配貨日期、退換貨日期,依我們向您另行通知之內容為準。
- 標示『安心配』商品類別,因商品屬性關係,將有專人與您約定送貨時間(可約定出貨日30天內日期)。※若為預購商品,以下單日網頁公告之配送日期,於一個工作天內(不含例假日)與您約定送貨時間。
- 針對大型商品(包括:大型家電、家具床墊、健身按摩器材、車類...等),我們將於完成收款確認後,一天內〈不含例假日〉將會有專人與您確認相關配送細節等的聯繫。偏遠地區、樓層費及其它加價費用,皆由廠商於約定配送時一併告知,廠商將保留出貨與否的權利。
- 依照客戶指定配送之商品(約配商品)接獲訂單逾30日您未通知出貨及受領商品,為了保障您的權益,本公司得取消訂單,請客戶重新下單購買。
- 如您收到商品,請依正常程序儘速檢查商品,若商品發生新品瑕疵之情形,您可申請更換新品或退貨,請直接點選聯絡我們。
- 若您對於購買流程、付款方式、退貨及商品運送方式有疑問,你可直接點選會員中心。
- 本公司收到您下單(要約)後,仍需確認交易條件正確、供貨商品有庫存或服務可提供。如有無法接受訂單之異常情形,或您下單後未能完成正常付款,應視為訂單(買賣契約)全部自始不成立或失效,本公司得於合理期間內通知說明拒絕接受訂單。請您重新依需求下單訂購。
- 本公司對於所販售具遞延性之商品或服務,消費者權益均受保障。如因合作廠商無法提供商品或服務,請與本公司聯繫辦理退貨或換成等值商品。
- ※特惠商品,不適用折價券
退換貨須知:
運送服務:
售後服務:
特別說明:
é11æ´»åçºç©æµç¹å¿æï¼ååè¥ç¡æ³æå®æ¥å°è²¨ï¼äº¦ä¸ç¬¦åå¿«éå°è²¨è³ åæ¢ä»¶ï¼è«è¦è«ã

請選擇、

信用卡。
信用卡。